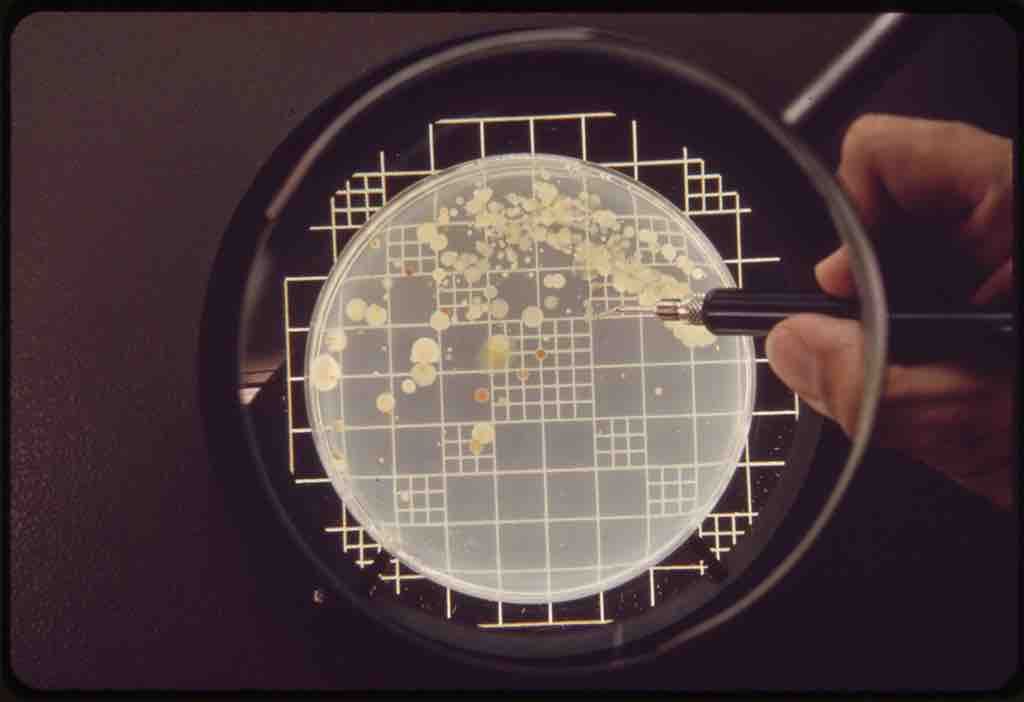

Concept
Version 7
Created by Boundless
Direct Counting
Source
Boundless vets and curates high-quality, openly licensed content from around the Internet. This particular resource used the following sources:
"EPA GULF BREEZE LABORATORY, THE MICRO-BIOLOGY LAB.
TAKING A BACTERIA COLONY COUNT - NARA - 546274."
http://commons.wikimedia.org/wiki/File:EPA_GULF_BREEZE_LABORATORY,_THE_MICRO-BIOLOGY_LAB._TAKING_A_BACTERIA_COLONY_COUNT_-_NARA_-_546274.jpg
Wikimedia
Public domain.